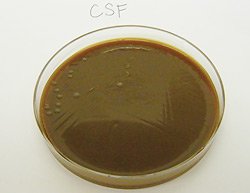

Ранее здоровый 5-летний мальчик был доставлен в отделение неотложной помощи с двухчасовым анамнезом болей в животе и лихорадкой до 39 градусов. После пробуждения в то же утро он выглядел хорошо и не жаловался. В школе у него поднялась температура, и его отправили домой. Впоследствии у него было несколько эпизодов диареи и бескровного, не обильной отрыжки.
У пациента не было значимого прошлого медицинского анамнеза, без истории предыдущих госпитализаций или операций. Он не принимал никаких лекарств и не имеет истории аллергии. У пациента не было никаких известных ему контактов с больными. Он жил дома с родителями и шестью братьями и сестрами, все из которых были здоровы. Там не было никакого контакта с животными или истории путешествий. Семейная история была неконституционной. Его прививки были актуальны, и он был эволюционно пригоден без каких-либо осложнений.
По прибытии в эд его физическое обследование было следующим: температура 39.2 градуса, частота сердечных сокращений 151 удар в минуту, частота дыхания 20 вдохов в минуту и насыщение кислородом 98% в воздухе комнаты. Поначалу он был настороже и не испытывал острой тревоги. Его зрачки были круглыми и реактивными, конъюнктива-прозрачной, а шея-гибкой, без признаков менингизма. Легкие были чисты для аускультации в двустороннем порядке. Исследование сердца было значимым для тахикардии, но не было отмечено ни шороха, ни трения, ни шума, а наполнение капилляров было менее двух секунд. Не было отмечено ни высыпаний, ни поражений кожи, а неврологическое обследование не выявило никаких нарушений.
Исходные лабораторные показатели были следующими: количество лейкоцитов составило 24 200/мм3 (с дифференцировкой 80% сегментоядерных нейтрофилов, 10% полос, 7% лимфоцитов и 3% моноцитов). Гемоглобин составил 13,3 г/дл, а количество тромбоцитов — 286 000 / мм3 . Аспартатаминотрансфераза была незначительно повышена при 45 Ед / л (0-37), но остальные ферменты печени, билирубин, химия сыворотки крови, почечные функциональные пробы и коагуляционные пробы находились в пределах нормы. Анализ мочи был ничем не примечательным.
Пациент наблюдался в течение нескольких часов. Первоначально у него было два эпизода небилиарного, бескровного эмезита и развилась лихорадка до 39.3 градусов. В течение следующих нескольких часов пациент продолжал казаться бодрым, а жизненные показатели оставались стабильными. Однако лихорадка не отступала, и он продолжал жаловаться на боли в животе. Он получил несколько болюсов изотонической жидкости и ондансетрон от тошноты. Компьютерная томография брюшной полости была получена для исключения аппендицита, который был отрицательным.
Вскоре после этого мать пациента уведомила персонал, что у ее сына произошел внезапный эпизод недержания кала и он стал минимально реагировать на вербальные стимулы. Теперь было замечено, что у него появились петехии на груди, которых не было несколькими часами ранее. После краткого дополнительного кислорода он стал более отзывчивым и жаловался на головную боль. Внутривенно вводили Цефтриаксон, дексаметазон и дополнительные жидкие болюсы. Была проведена люмбальная пункция, которая выявила глюкозу спинномозговой жидкости 54 мг/дл, белок 29 мг/дл, 112 ядросодержащих клеток (97% ПМНС) и 220 эритроцитов / мм3 . На пятне Грэма в спинномозговой жидкости не было видно никаких организмов. Ванкомицин был добавлен к его антибактериальному режиму, и он был переведен в детское отделение интенсивной терапии. Его кровяное давление впоследствии снизилось до 69 мм рт.ст./33 мм рт. ст., и он был минимально реагирующим. Больного интубировали, вводили центральный венозный катетер и вводили инотропные препараты.
Наиболее вероятным патогеном, связанным с этим серьезным развивающимся заболеванием, является:
- Neisseria meningitidis
- Streptococcus pneumoniae
- Грамотрицательный сепсис с энтеробактериями
- Риккетсия rickettsii
Врачи, рассматривая случай 5-летнего мальчика с болями в животе и лихорадкой, отмечают важность комплексного подхода к диагностике. Первоначально необходимо исключить острые хирургические состояния, такие как аппендицит или кишечная непроходимость. Симптомы могут указывать на вирусные или бактериальные инфекции, что требует внимательного анализа клинической картины и лабораторных исследований. Врачи подчеркивают, что у детей такие симптомы могут быть связаны с различными заболеваниями, включая гастроэнтерит или инфекции мочевыводящих путей. Важно также учитывать анамнез, включая недавние поездки или контакт с больными. Правильная диагностика и своевременное лечение помогут избежать осложнений и обеспечить быстрое восстановление здоровья ребенка.

Ответ
В граммовом пятне крови выявлялись грамотрицательные диплококки, а культура как крови, так и спинномозговой жидкости росла Neisseria meningitidisсеро группы в в течение 24 часов.
В течение первых пяти дней госпитализации пациенту потребовалась искусственная вентиляция легких, развилась тяжелая коагулопатия и стойкая гипотензия. Он был агрессивно поддержан несколькими инотропными агентами, свежезамороженной плазмой и переливаниями крови и активированным белком С в течение 96 часов. Ему была продолжена внутривенная антибактериальная терапия цефтриаксоном и ванкомицином. Примерно через пять дней он был экстубирован и выписан в отличном состоянии после 10 дней госпитализации. Вскоре после этого он вернулся в школу, и у него не было никаких доказательств неврологических или других последствий.
После подтверждения диагноза с ним связались сотрудники здравоохранения, а его родные и одноклассники были пролечены профилактическими антимикробными препаратами.
N. meningitidis является высокопатогенным организмом, который может вызывать менингит, фульминантный сепсис из-за менингококковой инфекции или и то, и другое. Несмотря на исключительную восприимчивость ко многим антибиотикам, ранняя диагностика и лечение имеют решающее значение, поскольку системный ответ хозяина может привести к быстрому прогрессированию до потенциально необратимых последствий или смерти. N. meningitidis, Haemophilus influenzae type b и Streptococcus pneumoniae исторически сложилось так, что наиболее распространенными причинами бактериального менингита у детей были бактериальные менингиты, хотя в развитых странах доля последних двух патогенов снизилась в результате применения эффективных детских вакцин. Как и у нашего пациента, симптомы не всегда изначально указывают на диагноз, но дети могут быстро ухудшаться и нуждаются в немедленном вмешательстве.
N. meningitidis колонизирует носоглоточный респираторный эпителий примерно у 3% людей. Передача происходит с непосредственным контактом человека с человеком или дыхательным воздействием капель. Считается, что бессимптомные носители являются основным источником инфекционных случаев. Колонизация носоглотки является распространенной и способствует развитию иммунитета хозяина. В большинстве случаев колонизация приводит к инвазивным заболеваниям. Инкубационный период для N. meningitidis обычно составляет менее четырех дней, но колеблется от одного до 10 дней.
Показатели заболеваемости менингококковой инфекцией составляют от одного до трех из 100 000 в развитых странах и от 10 до 25 из 100 000 в развивающихся странах. Ежегодно в Соединенных Штатах Америки происходит приблизительно от 1500 до 3000 случаев заболевания. Случаи заболевания чаще встречаются у детей в возрасте до 2 лет и у подростков в возрасте от 15 до 18 лет. Первокурсники колледжей, проживающие в общежитиях, и призывники на военную службу подвергаются значительно более высокому риску инвазивных менингококковых заболеваний. Другие факторы риска включают в себя воздействие на инфицированного человека (до 500 раз повышенный риск), терминальный комплемент (С5-С9) или дефицит пропердина и асплению.
Существует по меньшей мере 13 серогрупп, из которых A, B, C, Y и W135 отвечают примерно за 90% заболеваний человека. Эпидемиологическая разбивка в настоящее время в Соединенных Штатах оценивается как: B 30%, C 28% и Y 37%. Серогруппа В, для которой не существует эффективной вакцины, преобладает у младенцев, вызывая более 50% случаев заболевания у детей в возрасте до 2 лет.
Клинические признаки
Дети обычно присутствуют с неспецифическими симптомами, включая лихорадку, рвоту, миалгию, вялость, диарею и боль в животе.
Классические признаки менингококковой инфекции, такие как петехиальная или геморрагическая сыпь, изменения психического статуса и признаки менингита (рвота, головная боль, светобоязнь, жесткая шея, положительный знак Кернига или Брудзинского) могут не присутствовать изначально, но часто развиваются резко через 12 или более часов. Отсутствие признаков менингеальной раздражительности не исключает диагноза. Признаки шока могут включать боль в ногах, прохладные конечности, цианоз, замедленное пополнение капилляров и олигурию. Сосудистая проницаемость может также увеличиться в легких, приводящая к в дыхательному дистрессу, легочному отеку. Диссеминированное внутрисосудистое свертывание может проявляться подкожными кровоизлияниями, желудочным и / или десневым кровотечением и вытеканием из мест венипунктуры.
Пурпура фульминан встречается у 15-25% больных с менингококковой инфекцией. Раннее антибактериальное вмешательство при обеспечении адекватной перфузии может предотвратить это осложнение. Активированный протеин с доказал, что устраняет коагулопатию и может помочь уменьшить тяжесть повреждения. В тяжелых случаях может потребоваться проведение вскрытия и/или ампутации.
N. meningitidis — это немотивированный, аэробный, грамотрицательный диплококк, который является каталазо — и оксидазо-положительным. Он лучше всего растет на плитке шоколадного агара с 5% до 7% углекислого газа. Культуры крови положительны в 40% до 75% случаев, и культуры спинномозговой жидкости положительны в 50% до 90% пациентов которые не подвергались действию любой противомикробной терапии. Любое предварительное лечение антибиотиками быстро стерилизует спинномозговую жидкость и кровь, и культуры могут быть отрицательными всего лишь с одним часом антибиотикотерапии. Однако антибиотики не следует откладывать, чтобы дождаться люмбальной пункции, несмотря на эти изменения. Другие стерильные жидкости могут быть культивированы.
Латекс агглютинация тестирования с антителами к менингококковых капсульных антигенов могут быть использованы как диагностические экспресс-тесты на образцов спинномозговой жидкости, хотя чувствительность и специфичность значительно ниже для серогруппы B, чем для В и С. ПЦР для N. meningitidis, выделенных в крови и спинномозговой жидкости может быть использована для быстрого обнаружения, но не в настоящее время доступен в большинстве клинических лабораторий.
Первым шагом в управлении является раннее признание, поскольку прогрессирование до шока и диссеминированного внутрисосудистого свертывания может быстро развиваться, несмотря на агрессивную раннюю поддерживающую помощь. Внутривенно следует вводить антибиотики; наиболее распространен Цефтриаксон. До тех пор, пока окончательно не будет поставлен диагноз N. meningitidis, ванкомицин обычно добавляют для возможности высокорезистентного S. pneumoniae. Лабораторные тесты для включения полного анализа крови, химий сыворотки и печеночных энзимов, тестов свертывания крови, подсчета клеток спинномозговой жидкости и химий, так же, как культур крови и спинномозговой жидкости, должны быть получены. Подавляющее большинство североамериканских изолятов N. meningitidis остаются чувствительными к пенициллину, что делает это приемлемым выбором для терапии; однако в большинстве случаев вводят цефалоспорин третьего поколения. Достаточно пятидневного курса терапии.
Раннее распознавание и лечение шока и диссеминированного внутрисосудистого свертывания также имеют решающее значение в лечении менингококковой инфекции. При наличии признаков шока может потребоваться проведение агрессивной жидкостной реанимации и инотропной терапии. Использование стероидов для лечения либо септического шока или менингококкового менингита у детей является спорным, и эффективность не была установлена. Исследования с использованием активированного белка C или дротрекогина Альфа (Xigris, Eli Lilly) у пациентов с тяжелым сепсисом были многообещающими. Активированный протеин С оказывает антикоагулянтное и противовоспалительное действие. Результаты одного исследования показали, что у детей 28-дневная смертность от всех причин была снижена при более низкой частоте серьезных кровотечений, таких как внутричерепные кровоизлияния.
Когда пятилетний мальчик жалуется на боли в животе и лихорадку, это вызывает беспокойство у родителей и близких. Многие начинают обсуждать возможные причины недомогания. Некоторые вспоминают о вирусных инфекциях, которые часто сопровождаются такими симптомами, другие опасаются более серьезных заболеваний, таких как аппендицит. Важно отметить, что в этом возрасте дети часто сталкиваются с кишечными расстройствами, вызванными неправильным питанием или стрессом. Родители делятся опытом: кто-то успокаивает, что такие симптомы могут пройти сами, а кто-то настаивает на немедленном обращении к врачу. В любом случае, внимание к состоянию ребенка и своевременная медицинская помощь играют ключевую роль в его восстановлении.

Смертность и последствия
Несмотря на улучшенное вмешательство для этих пациентов, смертность остается в диапазоне от 8% до 10%. Самые высокие показатели смертности отмечаются в подростковом возрасте-до 20%. Последствия встречаются примерно у 11-19% пациентов, как правило, в диапазоне от четырех до 10 дней после начала системного заболевания. Иммунные комплекс-посреднические симптомы, наиболее обыкновенно артрит, происходят в приблизительно 15% из детей. Другие осложнения включают потерю пальцев или конечностей, перикардит с возможным прогрессированием до тампонады, дисфункцию черепного нерва VI, VII и/или VIII, постоянную потерю слуха, умственную отсталость, диссеминированную опорно-двигательную менингококкемию (поражение кожи, поражение суставов и теносиновит) и пневмонию. Неврологические последствия встречаются реже при менингококковом менингите, чем при H. influenzae и S. pneumoniae.
Консультативный комитет КДК по практике иммунизации рекомендует менингококковую вакцину для лиц высокого риска, включая первокурсников колледжей, проживающих в общежитиях , призывников, микробиологов и медицинских работников, регулярно подвергающихся воздействию N. meningitidis, а также людей с терминальным дефицитом комплемента или с фактической или функциональной аспенией. Любой человек, путешествующий в район с высоким уровнем заболеваемости менингококковой инфекцией, особенно в странах Африки к югу от Сахары, должен быть вакцинирован.
Четырехвалентная полисахаридная вакцина против N. meningitidis типов A, C, Y, W135, известная как MPSV4 (Menommune, Sanofi Pasteur), была одобрена в 1981 году и рекомендована пациентам высокого риска в возрасте старше 2 лет. Новая конъюгированная вакцина, известная как MCV4 (Menactra, Sanofi Pasteur), была одобрена в 2005 году и обеспечивает улучшенный и более длительный иммунитет к тем же четырем серотипам. В настоящее время Menactra разрешен к применению только у пациентов в возрасте от 11 до 55 лет. С 2006 года рекомендованная ACIP всеобщая вакцинация всех детей в возрасте от 11 до 12 лет является частью обычного графика вакцинации.
Химиопрофилактика должна быть назначена в течение 24 часов для тесного контакта человека с этим заболеванием. В школьных или дневных детских учреждениях дети, воспитатели и учителя, находящиеся в одном классе или комнате ухода за детьми, должны проходить профилактическое лечение. Профилактические антибиотики рекомендуются медицинским работникам, осуществляющим реанимацию полости рта, эндотрахеальную интубацию и отсасывание. Одобренное лечение включает рифампин или Цефтриаксон у детей и ципрофлоксацин у взрослых.
Данная статья размещена исключительно в общих познавательных целях посетителей и не является научным материалом, универсальной инструкцией или профессиональным медицинским советом, и не заменяет приём доктора. За диагностикой и лечением обращайтесь только к квалифицированным врачам, в государственных больницах и частных клиниках.
Вопрос-ответ

Почему у ребенка 5 лет может болеть живот?
Для детей 1-6 лет характерны кишечные инфекции вирусной или бактериальной природы, как правило, вызванные контактом с заболевшим или некачественной едой. Среди сопутствующих симптомов – боли в животе, рвота, диарея, высокая температура, головная боль, слабость.
Когда следует беспокоиться о болях в животе у ребенка?
Поводом для обращения за медицинской помощью в экстренном порядке могут служить следующие симптомы: Острые болевые ощущения продолжаются у ребенка более двух часов. Боли носят схваткообразный характер и продолжаются более 12 часов. У ребенка появилась рвота, в том числе с кровью или желчью.
Почему у мальчика может болеть живот?
Наиболее распространенные причины боли в животе у детей: запоры, гастроэнтерит, аппендицит. К причинам боли в животе у детей относятся: колики (у младенцев в возрасте до 3–4 недель), гастроэнтерит (наиболее часто вызываемый ротавирусами, аденовирусами, энтеровирусами),
Что можно дать ребенку от боли в животе?
Из медикаментозных препаратов педиатры рекомендуют Плантекс, Эспумизан и другие. Однако стоит помнить, что это лекарственные средства и давать их ребенку в качестве питья или для профилактики не стоит. Кроме того, можно избавить грудничка от мучений и совсем не прибегая к таблеткам.
Советы
СОВЕТ №1
Обратите внимание на симптомы. Если у вашего ребенка наблюдаются боли в животе, лихорадка, рвота или диарея, важно внимательно следить за их развитием. Запишите, когда начались симптомы и как они изменяются, чтобы предоставить врачу полную информацию.
СОВЕТ №2
Не откладывайте визит к врачу. Если симптомы не проходят в течение нескольких часов или ухудшаются, обязательно обратитесь к врачу. Быстрая диагностика может помочь избежать осложнений и обеспечить необходимое лечение.
СОВЕТ №3
Убедитесь, что ребенок получает достаточно жидкости. Лихорадка и рвота могут привести к обезвоживанию, поэтому важно предлагать ребенку питье, даже если он не хочет есть. Подходят вода, разбавленные соки или специальные растворы для регидратации.
СОВЕТ №4
Следите за диетой. Если у ребенка есть боли в животе, лучше избегать тяжелой и жирной пищи. Предложите легкие блюда, такие как рис, бананы или тосты, которые могут помочь успокоить желудок.